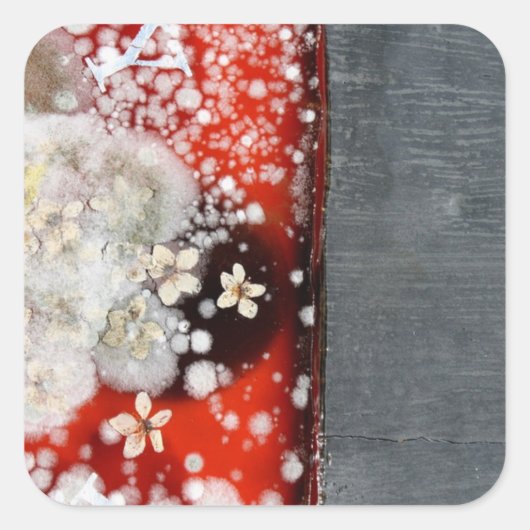
不死2 スクエアシール (正面)

シールについて
販売:
このデザインについて
不死2 スクエアシール
不死2 Millar Charlie /プライベートコレクション/ブリッジマン画像
自動翻訳
カスタマーレビュー
5つ星評価のうち星4.4全レビュー数 47
レビュー:47
類似商品のレビュー
5つ星評価のうち星5.0
5つ星評価のうち星5山下寛徳2018年12月29日 • 認証済みのご注文
Zazzleレビュープログラム
こちらの商品バンパーステッカーではなかったのですが、自家用車外部に貼ってますが十分に丈夫でした。イラストとてもかっこいい 印刷は何の心配もいらない素晴らしい出来
5つ星評価のうち星4.0
5つ星評価のうち星4お町支者♪2015年8月27日 • 認証済みのご注文
Zazzleレビュープログラム
今回、オートバイ用に購入しました。 色褪せは覚悟してますが、20枚入りなので、貼り替え貼り替えでしばらくは大丈夫そうですね(笑) 微妙なグラディションも良く表現されています。
できましたら、クルマやオートバイにも貼れる、高耐久性のシールをラインナップしてほしいです。 細かな表現もキレイで、大満足です。 要望としては、丸型や四角だけでなく、ロゴマークに沿ったカッティングのモノがあると助かります。
添付写真のように、ロゴ部だけをカットして貼りました。
5つ星評価のうち星5.0
5つ星評価のうち星5 S.2023年4月19日 • 認証済みのご注文
Zazzleレビュープログラム
期待以上の商品でした。さっそく持ち物に貼って愛用しています! 画質にもデザインにも大変満足しました。自分の名前入りのオリジナルシールが作れるのはとても魅力的です。
タグ
その他の情報
商品 ID: 217614529200617925
出品日: 2015/6/25 11:35
レーティング: G